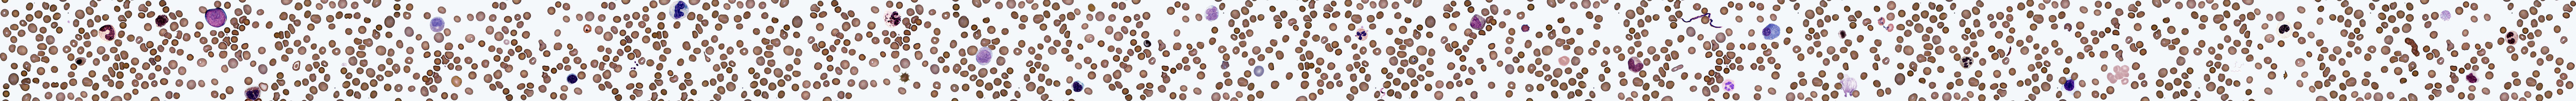

|

|

|

|

|

|

|

|
‹ Back to Main Atlas Atlas: Peripheral Blood - Test Your KnowledgeBelow is a slide at high magnification under an oil immersion lens.Scroll left and right to see various peripheral blood components. Click on an element for a brief description. Note: The elements seen, altogether, are not representative of normal peripheral blood, but are portrayed for learning and identification purposes.
|
|
Disclaimer: All information (including use of the photographs and charts) is strictly for individual educational purpose and should not be used for any other purpose. © 2012 Please read the Disclaimers Section for more information. |